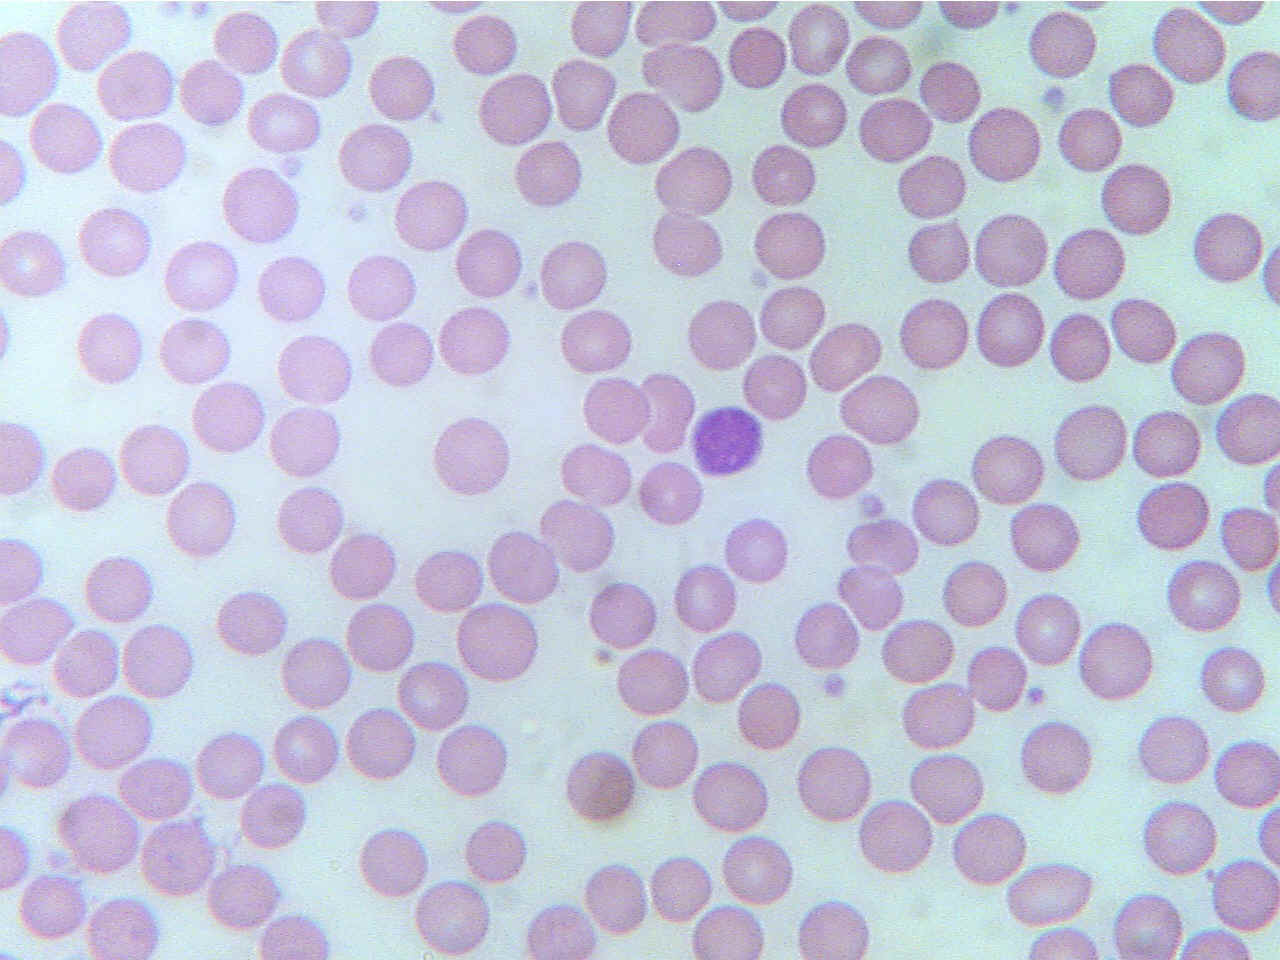

Normal blood (400X2.8) Sickle cell anemia (400X2.8)


Normal round RBCs and one WBC (blue cell) Some normal round RBCs, many pointed "sickle-shaped"
RBCs
* What is the cause of sickle cell anemia?
Return to Lab 01
Return to Slide List
Genetic disease - Sickle Cell Anemia (PH 1015) (pp. 17-18)
(Be
able to identify the slide of sickle cell anemia; differentiate between normal
blood and blood with sickle cell anemia.)
While many of the red blood cells have the normal donut appearance of
biconcave discs, notice that some are irregular in shape, often looking like
grains of rice or sickles (hence the name). Move the slide slightly, looking at
individual normal and sickle cells. As body oxygen level decreases, more and
more cells change from normal to sickle shape, blocking small blood vessels. The
sickle cells are also more fragile and break apart quickly causing anemia.
Normal blood
(400X2.8)
Sickle cell anemia
(400X2.8)

Normal round RBCs and one WBC (blue
cell)
Some normal round RBCs, many pointed "sickle-shaped"
RBCs
* What is the cause of sickle cell anemia?
Return to Slide List
8Copyright
2001 - Augustine G. DiGiovanna - All rights reserved.